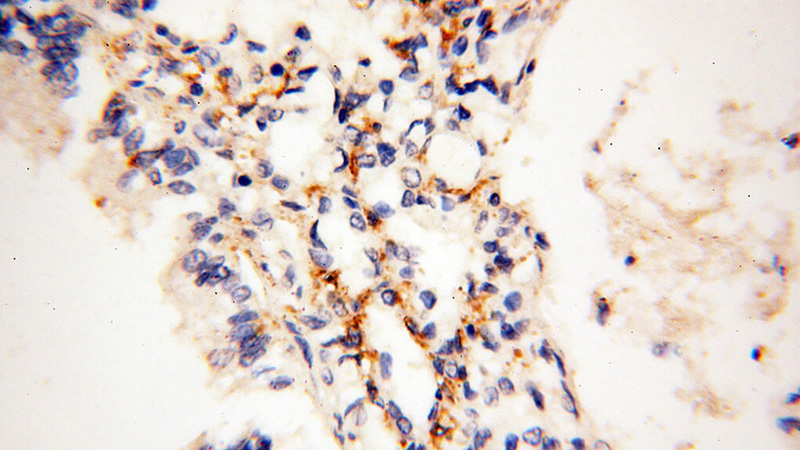
Immunohistochemical of paraffin-embedded human lung using Catalog No:112609(MICAL1 antibody) at dilution of 1:100 (under 40x lens)

-
Product Name
MICAL1 antibody
- Documents
-
Description
MICAL1 Rabbit Polyclonal antibody. Positive IP detected in HeLa cells. Positive WB detected in Jurkat cells, HEK-293 cells, HeLa cells, human brain tissue, mouse lung tissue. Positive IF detected in HeLa. Positive IHC detected in human lung tissue, human heart tissue, human ovary tissue, human placenta tissue, human skin tissue, human spleen tissue, human testis tissue. Positive FC detected in HeLa cells. Observed molecular weight by Western-blot: 120 kDa
-
Tested applications
ELISA, WB, IHC, IP, FC, IF
-
Species reactivity
Human, Mouse; other species not tested.
-
Alternative names
DKFZp434B1517 antibody; FLJ11937 antibody; FLJ21739 antibody; MICAL antibody; MICAL 1 antibody; MICAL1 antibody; NICAL antibody
-
Isotype
Rabbit IgG
-
Preparation
This antibody was obtained by immunization of MICAL1 recombinant protein (Accession Number: NM_022765). Purification method: Antigen affinity purified.
-
Clonality
Polyclonal
-
Formulation
PBS with 0.02% sodium azide and 50% glycerol pH 7.3.
-
Storage instructions
Store at -20℃. DO NOT ALIQUOT
-
Applications
Recommended Dilution:
WB: 1:1000-1:10000
IP: 1:500-1:5000
IHC: 1:20-1:200
IF: 1:50-1:500
-
Validations

IF result of MICAL1 antibody (Catalog No:112609) with Hela Cells (Methanol fixation) MICAL1 in Red (endogenous) and BioGFP-MICAL1-FL overexpression. Courtesy of Qingyang Liu, Utrecht University.

Jurkat cells were subjected to SDS PAGE followed by western blot with Catalog No:112609(MICAL1 antibody) at dilution of 1:1000

IP Result of anti-MICAL1 (IP:Catalog No:112609, 5ug; Detection:Catalog No:112609 1:1000) with HeLa cells lysate 2000ug.

Immunohistochemical of paraffin-embedded human lung using Catalog No:112609(MICAL1 antibody) at dilution of 1:100 (under 10x lens)
Immunohistochemical of paraffin-embedded human lung using Catalog No:112609(MICAL1 antibody) at dilution of 1:100 (under 40x lens)

1X10^6 HeLa cells were stained with 0.2ug MICAL1 antibody (Catalog No:112609, red) and control antibody (blue). Fixed with 90% MeOH blocked with 3% BSA (30 min). Alexa Fluor 488-congugated AffiniPure Goat Anti-Rabbit IgG(H+L) with dilution 1:1000.
-
Background
MICALs (Molecules Interacting with CasL) are atypical multidomain flavoenzymes with diverse cellular functions.There are three known isoforms, MICAL1, MICAL2 and MICAL3, as well as the MICAL-like proteins MICAL-L1 and MICAL-L2. MICAL1 has four conserved domains: an N-terminal flavin adenine dinucleotide (FAD) binding domain, a calponin homology (CH) domain, a Lin11, Isl-1 and Mec-3 (LIM) domain and a C-terminal coiled-coil (CC) domain. MICAL1 is reported to regulate actin stress fibers and be required for normal actin organization. It may also be involved in apoptosis through binding with NDR (nuclear Dbf2-related) kinases. This antibody specially recognizes MICAL1.
-
References
- Giridharan SS, Rohn JL, Naslavsky N, Caplan S. Differential regulation of actin microfilaments by human MICAL proteins. Journal of cell science. 125(Pt 3):614-24. 2012.
- Aggarwal PK, Veron D, Thomas DB. Semaphorin3a promotes advanced diabetic nephropathy. Diabetes. 64(5):1743-59. 2015.
Related Products / Services
Please note: All products are "FOR RESEARCH USE ONLY AND ARE NOT INTENDED FOR DIAGNOSTIC OR THERAPEUTIC USE"
